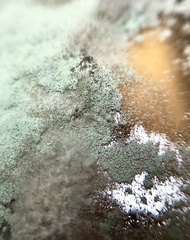
Penicillium digitatum
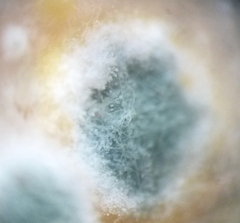
Penicillium digitatum
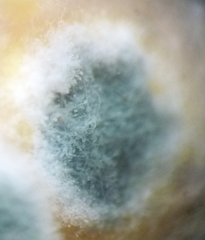
Penicillium digitatum
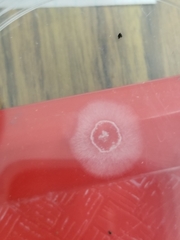
Penicillium digitatum
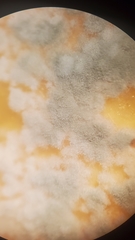
Penicillium digitatum

Penicillium digitatum: taxon details and analytics
- Domain
- Kingdom
- Fungi
- Phylum
- Ascomycota
- Class
- Eurotiomycetes
- Order
- Eurotiales
- Family
- Aspergillaceae
- Genus
- Penicillium
- Species
- Penicillium digitatum
- Scientific Name
- Penicillium digitatum
Summary description from Wikipedia:
Penicillium digitatum
Penicillium digitatum () is a mesophilic fungus found in the soil of citrus-producing areas. It is a major source of post-harvest decay in fruits, and is responsible for the widespread post-harvest disease in Citrus fruit known as green rot or green mould. In nature, this necrotrophic wound pathogen grows in filaments and reproduces asexually through the production of conidiophores and conidia. P. digitatum can also be cultivated in the laboratory setting. Alongside its pathogenic life cycle, P. digitatum is also involved in other human, animal, and plant interactions, and is currently being used in the production of immunologically based mycological detection assays for the food industry.
...Penicillium digitatum in languages:
- English
- citrus green mold
Images from inaturalist.org observations:
We recommend you sign up for this excellent, free service.